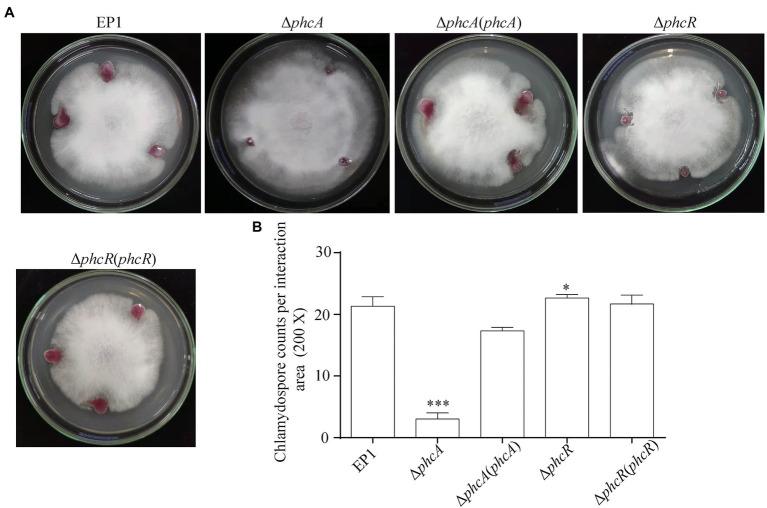
https://cdn.ncbi.nlm.nih.gov/pmc/blobs/d53d/9197120/2883db1b4f0d/fpls-13-903310-g005.jpg

在……中,PhcA和PhcR对雷索拉霉素生物合成的调控作用相反。 (原英文文本不完整,推测补充后的完整翻译)
PhcA and PhcR Regulate Ralsolamycin Biosynthesis Oppositely in .
作者信息
Li Peng, Cao Xiulan, Zhang Liwen, Lv Mingfa, Zhang Lian-Hui
机构信息
Ministry of Education Key Laboratory for Ecology of Tropical Islands, Hainan Provincial Key Laboratory for Tropical Plant and Animal Ecology, College of Life Sciences, Hainan Normal University, Haikou, China.
Biotechnology Research Institute, The Chinese Academy of Agricultural Sciences, Beijing, China.
出版信息
Front Plant Sci. 2022 May 27;13:903310. doi: 10.3389/fpls.2022.903310. eCollection 2022.
Ralsolamycin, one of secondary metabolites in , is known to be involved in crosstalk between and fungi. Ralsolamycin formation is catalyzed by two-hybrid synthetases of RmyA (non-ribosomal peptide synthetase) and RmyB (polyketide synthase). A methyltransferase PhcB catalyzes formation of 3-OH MAME or 3-OH PAME, signals for the quorum sensing (QS) in , while PhcB positively modulates ralsolamycin biosynthesis. A two-component system of PhcS and PhcR can response these QS signals and activate expression. Here, we experimentally demonstrated that deletion of (Δ) substantially impaired the ralsolamycin production and expression of and in strain EP1, and failed to induce chlamydospore formation of plant fungal pathogen f. (stran FOC4). However, deletion of significantly increased ralsolamycin production and expression of and , and mutants exhibited enhanced ability to induce chlamydospore formation of FOC4. Results of the electrophoretic mobility shift assay suggested that both PhcA and PhcR bind to promoter of operon. Taken together, these results demonstrated that both PhcA and PhcR bind to promoter of operon, but regulate ralsolamycin biosynthesis in an opposite way. It could extend our knowledge on the sophisticated regulatory networks of ralsolamycin biosynthesis in .
雷索拉霉素是[具体物质]中的次生代谢产物之一,已知其参与[具体物质]与真菌之间的串扰。雷索拉霉素的形成由RmyA(非核糖体肽合成酶)和RmyB(聚酮化合物合成酶)的双杂交合成酶催化。甲基转移酶PhcB催化3-OH MAME或3-OH PAME的形成,这是[具体物质]群体感应(QS)的信号,而PhcB正向调节雷索拉霉素的生物合成。PhcS和PhcR的双组分系统可以响应这些QS信号并激活[具体基因]表达。在这里,我们通过实验证明,在菌株EP1中缺失[具体基因](Δ)会严重损害雷索拉霉素的产生以及[具体基因]和[具体基因]的表达,并且无法诱导植物真菌病原体[具体真菌]f. [具体菌株](菌株FOC4)形成厚垣孢子。然而,缺失[具体基因]显著增加了雷索拉霉素的产生以及[具体基因]和[具体基因]的表达,并且[具体基因]突变体表现出增强的诱导FOC4形成厚垣孢子的能力。电泳迁移率变动分析结果表明,PhcA和PhcR都与[具体操纵子]的启动子结合。综上所述,这些结果表明PhcA和PhcR都与[具体操纵子]的启动子结合,但以相反的方式调节雷索拉霉素的生物合成。这可以扩展我们对[具体物质]中雷索拉霉素生物合成复杂调控网络的认识。